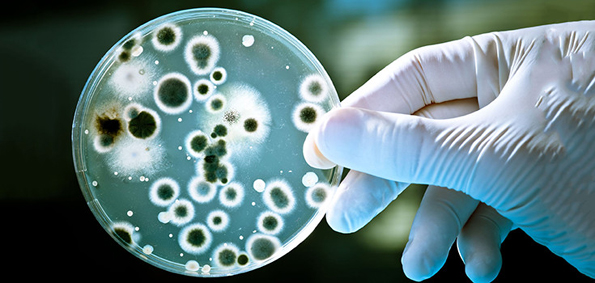

Најстрашните работи на светот што навистина постојат
Кога ќе помислите на зборовите „страв“ и „хорор“ што е првото нешто што ви паѓа на памет? Духови? Зомбиња? Страшни филмови? Колку од овие работи се вистински? Што е со големите пајаци, ужасните болести и сериски убијци? Мора да признаеме дека реалноста е многу почудна и пострашна од фантазијата. Па, доколку си барате причина за да не заспиете вечерва, прочитајте ги најстрашните работи на светот што навистина постојат…
Самоубиствено растение

Станува збор за најопасната грмушка во Австралија позната под латинското име Dendrocnide moroides. Нејзините листови имаат мали влакна полни со отров. Ако ги допрете, ќе почувствувате како кожата да ви гори од киселина и тоа може да трае со месеци доколку не ги отстраните сите влакна. Се зборува дека некој човек ги употребил листовите како тоалетна хартија и болката била толку неподнослива што се самоубил. Ботаничарите кои дошле до контакт со ова растение ја опишуваат болката на следниов начин:
„Станува збор за најлошата болка што можете да си ја замислите. Чувството е како да сте биле изгорени со жешка киселина и изложени на електрошокови истовремено. Алергиската реакција се развива постепено и предизвикува екстремно чешање и огромни осипи.“
Дефинитивно не би сакале да се најдете во близина на ова опасно растение.
Алцхајмерова болест

Замислете си да изгубите сѐ и сите луѓе што некогаш сте ги познавале. Последиците од Алцхајмеровата болест не се забавни за гледање ни кога му се случуваат на некој ваш близок човек. Многу луѓе ја поврзуваат оваа ментална болест со хорор филм и тие не се многу далеку од вистината. Најстрашните филмови раскажуваат за вистински случки од животот.
Биолошко војување
Сознанието дека постојат луѓе кои навистина се обидуваат да создадат вируси и бактерии што би можеле да ги искористат како оружје е многу страшно. Непријателите против кои не можете да се борите се пострашни од кои било бомби и пушки. Секако дека сите војни се ужасни, но биолошките војувања се посебно застрашувачки. Користењето биолошки оружја датира уште од антички времиња. Постојат докази дека чумата од туларемија која се појавила во 14 век п.н.е. во Источниот Медитеран била еден вид биолошко војување. Денес, со сета таа напредна технологија, станува сѐ полесно и полесно да се глуми Бог.
Амеба што го јаде мозокот

Нејзиното латинско име е Naegleria fowleri. Станува збор за паразит што може да влезе во човечкото тело преку носот доколку пливате во загадена вода. Оттука, тој патува до мозокот каде што може да предизвика смртоносно воспаление.
Време

Многу луѓе се плашат од времето кое постојано тече и минува. Секој ден старееме и стравот од тоа дека еден ден ќе се разбудиме стари и беспомошни без да постигнеме ништо во животот е навистина голем и вистински. Егзистенцијалната криза е нешто што секојдневно се исмејува иако би требало да ѝ се обрне повеќе внимание и да се подигне свеста за негативните последици што може да ги предизвика.
Ируканџи – мала, отровна медуза

Станува збор за многу мала и нежна медуза (толку е нежна што не може да се чува во аквариум, бидејќи удирањето во стаклото може да ја убие) со неверојатно ужасен убод. Ако ве боцне оваа медуза, ќе го добиете синдромот Ируканџи кој научниците го опишуваат како „чувство на неизбежна пропаст“. Пациентите мислат дека ќе умрат и толку многу се сигурни во тоа што буквално ги молат докторите да ги убијат.
Продолжете на следната страница за останатите страшни работи што навистина постојат…






























